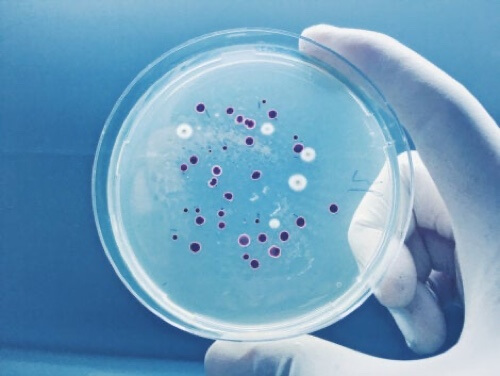
Piastra di Petri con coltura.

Coltura delle feci: in cosa consiste?

La coltura delle feci, o coprocoltura, è un esame che permette di risalire ai batteri che provocano malattie nell’apparato digerente. Viene impiegata anche negli studi scientifici sui batteri e i parassiti presenti nell’intestino.
Il nostro organismo entra spesso in contatto con parassiti, virus e batteri che causano infezioni e disturbi gastrointestinali. Oltre a ciò, alcune patologie come la colite, il tumore allo stomaco e l’ulcera gastrica, si manifestano con la presenza di sangue nelle feci. In questi e in altri casi, la coltura delle feci rappresenta un test di screening obbligatorio.
Informazioni riguardo le colture microbiologiche
La coltura microbiologica è un metodo per la moltiplicazione di microrganismi in un medium sterile, in genere batteri, al fine di individuare gli agenti patogeni causa di malattie. In sintesi, consiste nel fornire ai microrganismi l’ambiente ideale per il loro sviluppo.
La semina dei campioni biologici del paziente proviene da espettorato, tamponi salivari, porzioni di pelle o feci; questi vengono conservati in contenitori denominati piastre di Petri, che contengono una sostanza solida con agar.
Molti patogeni richiedono condizioni specifiche per crescere, motivo per cui ogni terreno di coltura viene sviluppato in base al microrganismo oggetto della ricerca. Tra le variabili troviamo:
- La disponibilità di nutrienti necessari per la crescita dei batteri.
- Presenza o assenza di ossigeno e altri gas.
- Adeguate condizioni di umidità.
- Luce ambientale
- Acidità o alcalinità.
- Temperatura.
- Sterilità dell’ambiente.
Le condizioni dei terreni di coltura possono quindi variare a seconda dei microrganismi da individuare, Una volta rilevata la loro crescita sulla piastra, i campioni vengono isolati e analizzati al microscopio per risalire alla specie che causa la malattia.
Oltre a ciò, esistono diverse colorazioni per l’identificazione dei batteri. Nella coltura si colloca un colorante che viene assorbito dai microrganismi. La più comune per uso medico è la colorazione di Gram.
Leggete anche: Virus e batteri: qual è la differenza?
In cosa consiste la coltura delle feci?
In base a quanto esposto, la coltura delle feci non è altro che una coltura microbiologica basata sulla raccolta di feci come campione del paziente. Viene impiegata soprattutto per studiare i casi di diarrea persistente o ricorrente senza causa nota.
Il prelievo dei campioni fecali si rende necessario nei casi di infezioni enteriche che non migliorano in due o tre giorni. Tra i microrganismi patogeni che possono essere identificati attraverso la coltura troviamo: Salmonella, Campylobacter, Helicobacter, Shigella, Yersinia, Clostridium difficile e Staphylococcus aureus.
Raccolta del campione
Riportiamo i passaggi per la raccolta del campione di feci:
- Le feci del paziente vengono raccolte in un contenitore a imboccatura larga e a chiusura ermetica, nel quale verrà posto un volume minimo di due o quattro grammi di feci pastose oppure di cinque o dieci millilitri di feci liquide.
- Non si considerano validi i campioni fecali esposti all’aria per due o più ore, quelli contaminati da urina o da residui di carta igienica.
- Il campione prelevato viene seminato nel terreno di coltura più appropriato per la proliferazione dei microrganismi patogeni.
- Se nel primo campione non viene rilevata la presenza di enteropatogeni, sarà necessario raccogliere altri due campioni in giorni diversi.
- Una volta identificati i batteri patogeni, viene prescritto l’antibiotico del caso.
A cosa serve la coltura delle feci?
Le colture microbiologiche servono a rilevare diverse patologie mediante l’identificazione dei batteri responsabili; ciò è possibile attraverso la semina del campione fecale e la successiva colorazione. Si esaminano anche eventuali uova o resti di parassiti.
Secondo i Centers for Disease Control and Prevention (CDC), i parassiti come la tenia possono essere identificati attraverso la coltura delle feci perché le loro uova sono presenti negli escrementi dell’individuo. Allo stesso modo, questo esame consente di rilevare la presenza di sangue occulto nelle feci, non visibile a occhio nudo.
Limiti della coltura delle feci
Nel mondo delle colture microbiologiche non tutto va alla perfezione. Non sempre si ottengono risultati, i quali dipendono in larga parte dalla qualità del campione. Esistono, di fatto, alcuni rischi nell’identificazione delle malattie attraverso la coltura delle feci.
In primo luogo, non tutti gli enteropatogeni vengono ricercati in modo sistematico. Dato che il terreno di coltura è specifico per ciascun microrganismo, quelli meno comuni, come il Bacteroides fragilis, Edwarsiella dela o Escherichia alberti, o sconosciuti potrebbero non proliferare.
Altri studi sostengono che le colture delle feci non sono adatte in caso di ospedalizzazione che supera i tre giorni, poiché la causa della diarrea non è attribuibile ad agenti patogeni intestinali. In questi casi si opta per la tecnica di rilevamento PCR, che individua i geni specifici di un microrganismo nel campione fecale.

Può interessarvi anche: Helicobacter Pylori: rimedi naturali per combattere questo batterio
Cultura delle feci: cosa ricordare?
Le colture microbiologiche sono utili per individuare batteri enterici patogeni, parassiti e sangue nelle feci. Ciononostante, a causa dei costi elevati e delle tempistiche, si effettuano solamente nei pazienti la cui condizione epidemiologica ne giustifichi l’impiego.
In ogni caso, se durante una degenza ospedaliera si esegue una coltura delle feci, non c’è motivo di allarmarsi. I medici cercano di risalire alla causa della malattia gastrointestinale in modo da somministrare il farmaco più appropriato.
Tutte le fonti citate sono state esaminate a fondo dal nostro team per garantirne la qualità, l'affidabilità, l'attualità e la validità. La bibliografia di questo articolo è stata considerata affidabile e di precisione accademica o scientifica.
- Vila, J., Gómez, M. D., Salavert, M., & Bosch, J. (2017). Métodos de diagnóstico rápido en microbiología clínica: necesidades clínicas. Enfermedades Infecciosas Y Microbiología Clínica, 35(1), 41-46.
- Los medios de cultivo, microinmuno. Recogido a 27 de junio en http://www.microinmuno.qb.fcen.uba.ar/SeminarioMedios.htm.
- López-Jácome, L. E., Hernández-Durán, M., Colín-Castro, C. A., Ortega-Peña, S., Cerón-González, G., & Franco-Cendejas, R. (2014). Las tinciones básicas en el laboratorio de microbiología. Investig. en discapacidades, 3(1), 10-18.
- Cultivo (microbiología), wikipedia. Recogido a 27 de junio en https://es.wikipedia.org/wiki/Cultivo_(microbiolog%C3%ADa)
- Cuesta, F. S., López, F. R., González, A. I., & Díaz, M. L. (2002). Indicaciones y valoración clínica del coprocultivo. Medicine-Programa de Formación Médica Continuada Acreditado, 8(61), 3273-3275.
- Blu, A., León, E., Román, J. C., Chanqueo, L., & García, P. (2005). Evaluación del rendimiento del coprocultivo en pacientes hospitalizados. Revista chilena de infectología, 22(1), 58-62.
- Teniasis diagnóstico, CDC. Recogido a 27 de junio en https://www.cdc.gov/parasites/taeniasis/es/diagnostico.html.
Questo testo è fornito solo a scopo informativo e non sostituisce la consultazione con un professionista. In caso di dubbi, consulta il tuo specialista.







